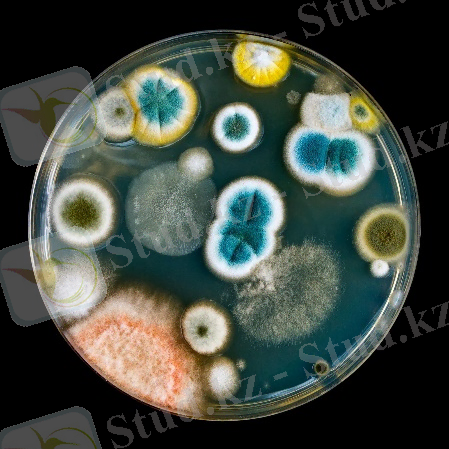

Практикалық жұмыс №1. Тағам өндірісіндегі тоңазыту техникасының негіздері: микроағзалардың температуралық жіктелуі, өмірлік фазалары және төмен температуралардың әсері


Құтжан Таңшолпан Қанатқызы
Практикалық жұмыс №1
Модуль 1: Тағам өндірісіндегі тоңазыту техникасының негіздері
1. Температуралық шарттарға байланысты микроағзалардың жіктелуі?
2. Микроағзалардың өмірлік фазалары ?
3. Төменгі етуі ?
4. -8 °С температурадақандай микроағзаларөмір сүре алады?
Микроорганизмдер - тек қана микроскоппен көруге болатын өте ұсақ организмдер. Бұларды алғаш рет 17 ғасырда голланд ғалымы А. В. Левенгук ашқан. Микроорганизмдер арасында прокариоттар және эукариоттар тобына жататындары бар. Кейде Микроорганизмдерге вирустарды да жатқызады. Микроорганизмдерді зерттейтін ғылым саласы - микробиология. Микроорганизмдердің басым көпшілігі бір клеткалы организмдер. Олар, көбінесе, қарапайым бөліну арқылы тез көбейеді. Көп клеткалы организмдерге тән өте күрделі жынысты көбею процессі бұлардың көбінде болмайды.
Микроорганизмдер физиологиялық және биохимиялық қасиеттері жағынан әртүрлі. Олардың кейбіреулері басқа организмдер өніп-өсе алмайтын ортада тіршілік етуге бейімделген. Мысалы, 70 - 105 0 С ыстықта, жоғары деңгейдегі радиацияда және концентрациясы өте күшті қышқылды немесе сілтілі орталарда, NaCl-дың жоғары, оттек жоқ жерде (анаэробты жағдайда) тіршілік ете алатын микроорганизмдер белгілі. Олар өте төмен температурада да, құрғақшылық ортада да көбейе алады. Кейбір бактериялар мен балдырлар өз клеткасына қажетті барлық заттарды синтездеу үшін СО 2 -ні пайдаланады, бұларды автотрофтар деп атайды. Бұлардың ішіндегі кейбіреулері (мысысалы, сүт қышқылы бактериялары және қарапайымдылар) өздерінің дамуына қажетті өсу факторларын, яғни дайын витаминдер, амин қышқылдары немесе т. б. органикалық заттарды өздері синтездей алмайды. Мұндай микроорганизмдерді - ауксотрофтар деп атайды.
Температура шарттарының қатынасына байланысты микроағзаларды үш топқа бөледі:
- Термофильді
- мезофильді
- психрофильді
Термофильді микроағзалар- 20-80 0 С температура аралығында көбейеді, ал 50-75 0 көбейуіне тиімді температура болып келеді, ал мезофильдер 5-57 0 С температурада, психрофильдер +10 0 -10 0 С температурада өсуге қабілетті.
Тамақ өнімдерін суықпен өңдеу жағдайында дамитын микро-ағзалар психрофильдер болып табылады .
Факультативті психрофильдер - мезофиль тәртібіне жақын температурада өмір сүреді және облигатты психрофильдер- төменгі температурада көбеюге қабілетті.
Психрофильді бактериялар қышқылдылығы аз ет, балық өнімдері, қышқыл емес сүт және көкөніс өнімдерінде -5÷-8 0 С температурада белсенді түрде көбейеді. Психрофильді көгерткіштердің көбі мұздатылған өнімдерде белсенді түрде дамиды. Көгерткіштер және сол сияқты ашытқылар қышқыл ортада дамиды. Олар аэробты түрлеріне жататын, яғни көгерткіштер -2÷-3 0 С температурада өседі, одан төменгі температурада дамуын төмендетеді. Бірақ, кейбір көгерткіштердің түрлері -8÷-10 0 С температурада дамуын тоқтатады. Көбею мен өсу әр түрлі температурада жүреді. Е. coli бактериясының көбеюі 7, 3 0 С температурада тоқтаса, ал өсуі жалғаса береді.
Микроағзалардың өсуінің 8 фазасы:
1) Лаг-фаза -бактерия жасуларының санын сипаттайтын даму стадиясы. Микроағзалар сыртқы ортаға үйреніп қалады да, осыдан төменгі температурада олардың саны азаяды. Лаг-фазаның ұзақтығы микроағзалардың түріне, көректік ортасы және температруасына байланысты.
2) Өсуді жылдамдату фазасы (б) -микроағзалардың дамуында жылдам жүреді.
3) Өсудің логарифмдік фазасы (в) -бактерия жасушаларының даму жылдамдығында тез жүреді.
4) Өсуді тоқтату фазасы (г) .
5) Микроағзалардың ең жоғарғы (концентрациясы) шоғырлану және тұрақты фазасы (д) . Бұл сатыда микроағзалардың шоғырлануы сыртқы орта шартымен салыстырғанда тұрақты. Олардың өлуі мен өмір сүруі бірдей қарқында болады. Тәжірибе мәліметтеріне сүйене отырып, бұл фазадағы 1г өнімдегі бактерия жасушаларының саны 10 9 -10 10 -ға дейін болады.
6) Микроағзалардың өлуін жылдамдататын фаза (е) -зат алмасу процессіне жағымсыз жағдайын туғызады.
7) Өлу фазасы (ж) - өнімнің өзіндік іс-әрекеті әсерінен микроағзалар жылдам өледі.
8) Соңғы тұрақты фаза (қалыптасу фазасы) (з) .
Әр түрлі фазада микроағзалардың өмір сүруін үйрену іс-тәжірибеде үлкен мәнге ие. Осыдан, а және б фазасының ұзақтығы қысқарады, бастапқы микроағзалардың саны көп болса, яғни тамақ өнімдерінің бастапқы зақымдалуы көп болғандықтан логарифмдік фаза тез басталады.
Температураның төмендеуі лаг-фаза ұзақтығы және логарифмдік фазаның сипаттамасына әсер етеді. Температура төмен болған сайын, лаг-фаза ұзақтықтайды, логарифмдік фаза жоғары болып, микроағзалардың дамуы жай жүреді. Төменгі температураға сезімтал және сезімтал емес микроағзалар пайда болады. Төменгі температрураға сезімтал вегатативті көгерткіш саңырауқұлақтар және ашытқылар болып есептеледі. Төменгі температурада Е. coli, Pseudomonas-Achromobacter және Salmonella тобына жататын бактериялар өледі. Төменгі температураға S. aureus бактериялары тұрақты келеді. Clostridium бацилла төменгі температураға сезімтал емес.
Төмен температураларға микроағзалардың әсер етуі үш фактормен іске асады: температура, төмендету жылдамдығы, уақыттың әсер етуі. Төмен температураның микроағзаларға әсері микробты жасушадағы су күйінің өзгерісіне байланысты. Ең зиян келтіретін жағдай жасуша ішіндегі мұздың пайда болуы. Бұл сыртқы және ішкі жасуша ерітіндісінің концентрациясының жоғарылауын, ақуыз денатурациясы және сіңімділіктің (Барьер) бұзылуына алып келеді. Суықпен микроағзаларды зақымдау мұздың түзілуінсіз-ақ жүреді. Төменгі осмостық қысым жағдайында өте жылдам салқындату кезінде суықтың нәтижесінен бактерия жасушалары өледі. Сондықтан төменгі температурада липидті мембраналардың бүлінуі мен нуклейн қышқылдарының бұзылуына байланысты.
... жалғасы- Іс жүргізу
- Автоматтандыру, Техника
- Алғашқы әскери дайындық
- Астрономия
- Ауыл шаруашылығы
- Банк ісі
- Бизнесті бағалау
- Биология
- Бухгалтерлік іс
- Валеология
- Ветеринария
- География
- Геология, Геофизика, Геодезия
- Дін
- Ет, сүт, шарап өнімдері
- Жалпы тарих
- Жер кадастрі, Жылжымайтын мүлік
- Журналистика
- Информатика
- Кеден ісі
- Маркетинг
- Математика, Геометрия
- Медицина
- Мемлекеттік басқару
- Менеджмент
- Мұнай, Газ
- Мұрағат ісі
- Мәдениеттану
- ОБЖ (Основы безопасности жизнедеятельности)
- Педагогика
- Полиграфия
- Психология
- Салық
- Саясаттану
- Сақтандыру
- Сертификаттау, стандарттау
- Социология, Демография
- Спорт
- Статистика
- Тілтану, Филология
- Тарихи тұлғалар
- Тау-кен ісі
- Транспорт
- Туризм
- Физика
- Философия
- Халықаралық қатынастар
- Химия
- Экология, Қоршаған ортаны қорғау
- Экономика
- Экономикалық география
- Электротехника
- Қазақстан тарихы
- Қаржы
- Құрылыс
- Құқық, Криминалистика
- Әдебиет
- Өнер, музыка
- Өнеркәсіп, Өндіріс
Қазақ тілінде жазылған рефераттар, курстық жұмыстар, дипломдық жұмыстар бойынша біздің қор #1 болып табылады.



Ақпарат
Қосымша
Email: info@stud.kz